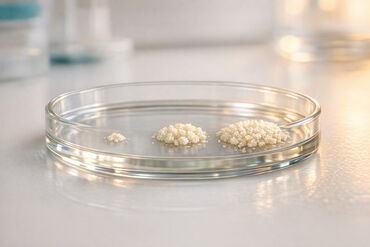
69a9d13a12de151ab02776c1 1772741645354

BioBanking Services
Banking your baby’s stem cells and perinatal tissues is one of the most important choices you’ll ever make for your child, and we’re here to help! You’ll find all the insights and information you’ll need to make the best decision for your family.

Ultimate Guide to Cord Blood Collection Kits
Practical guide to cord blood collection kits: what's included, how to use them, choosing the right kit, shipping, storage, and banking options.

Checklist for Quality Assurance in Cord Blood Storage
Checklist of accreditations, cryopreservation standards, temperature monitoring, testing and traceability to evaluate cord blood banks for long-term stem cell preservation.

AABB Accreditation Process Explained
The industry gold standard for cord blood banks ensures strict donor safety, validated processing, and long-term cryostorage confidence.

The Ultimate Biohack for Your Baby’s Future: A Guide to Cord Blood Banking
Learn how cord blood banking stores newborn stem cells, compares private vs public options, costs, collection, and future medical uses.

Why Cord Blood Banking Belongs on Your 2nd Trimester To-Do List
Deciding on cord blood banking in your second trimester gives you time to research providers, secure a collection kit, and plan for delivery.
What is Stem Cell Expansion? Maximizing Your Cord Blood Investment
Explains how ex vivo stem cell expansion multiplies cord blood HSCs to enable adult transplants, faster engraftment, and broader treatment options.

How Scaffold-Based Culturing Expands Cord Blood Stem Cells
How 3D scaffold culturing boosts cord blood CD34+ expansion, preserves stemness and homing markers, and enables scalable clinical production for transplants.

History of Cord Blood Banking
Trace cord blood banking from 1980s discovery to modern regenerative therapies, covering key transplants, public/private banks, and current research.

Americord vs. Other Banks: Cost Comparison
Compare Americord’s upfront and 20-year cord blood costs, storage model, processing method, and $110,000 quality guarantee versus competitors.
